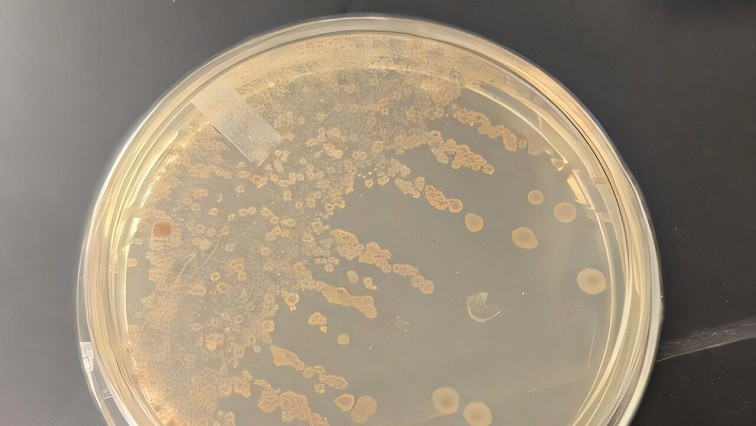

Led by Dr. Yilan Liu, a Waterloo chemical engineering professor, the international research team altered bacteria found in the human gut, or gastrointestinal tract, to dramatically increase the number of bubble-shaped nanoparticles they secrete.
Those particles, known as bacterial membrane vesicles (BMVs), are widely recognized for their potential impact in biomedicine, but their use has been slowed by challenges, including a low rate of natural secretion.
Liu and her team tackled that problem by making two key changes to the bacteria, including the insertion of a shell protein into their membranes. The changes resulted in a 140-fold increase in the yield of BMVs, which are about a thousand times smaller than the width of a human hair.
“This strategy enables us to produce BMVs with unprecedented efficiency without using chemicals,” Liu said. “Current methods rely on chemical processes to increase secretion. We've engineered bacteria to optimize their vesicle production naturally, resulting in a cleaner, more sustainable approach."
Initial testing revealed that the engineered bacteria activated the immune system in the gut, paving the way for the treatment of medical conditions, such as Inflammatory Bowel Disease (IBD), in which patients often have underactive immune systems.
Researchers used fluorescence imaging to track the engineered bacteria moving from the stomach to the intestines, proving that they could be used to deliver nutrients or drugs directly to the gut.
"This advancement in bacterial engineering has the potential to be a transformative platform for next-generation vaccines, therapeutics and nutrient delivery," said Liu. "This new process could profoundly impact global health by making biomedical treatments more efficient, accessible and affordable."
The next step for researchers is applying their new technique to pathogenic bacteria, like those used in the meningitis vaccine, for potential productivity increases and cost savings.
They are also investigating the use of BMVs as probiotic supplements to improve nutrient absorption, especially for fat-soluble nutrients such as beta-carotene. Collaborators for that project are now being sought.
Their study recently appeared in ACS Nano.
Read the original article on University of Waterloo.